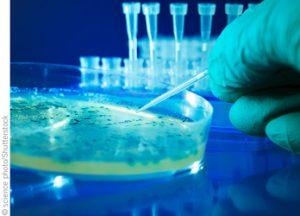
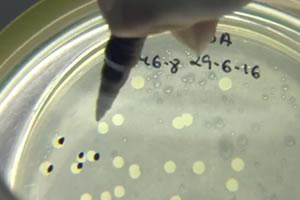
microbiologia

La Agència de Salut Pública de Catalunya ha publicado un documento, dirigido a los veterinarios de mataderos de aves de corral, para ayudarles a detectar durante los controles oficiales aquellas canales que deben ser retiradas del mercado para consumo humano. Se trata de una herramienta muy útil, que facilita la identificación en las canales de 51 patologías diferentes y el posible origen de diversas alteraciones organolépticas.